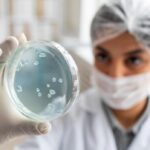

Risk management has now become an essential component to Korean investors navigating their courses to more complex financial markets. The respondents are emphasizing structured approaches, which unite planning, analytical instruments, and discipline. These practices, when put together, will enable the investors to seize opportunities and hedge their capital against abrupt market trends and unstable market dynamics. Proper risk management ensures that even during unexpected market swings, losses are minimized and portfolio performance remains stable over the long term.
Risk management is everything about tracking volatility in the market. The participants of the forex market know the currency fluctuations, economic trends and geopolitical events that could influence the mood of the market. Having this information, these signals allow the participants to make proactive adjustments and balance their portfolios to prevent exposure to high and unexpected swings. Investors can place themselves in a tactical position by becoming aware of the possible effects of economic releases or global events that may cause them to make reactive and emotion-based trading decisions that can destroy returns.
The world has changed the approaches to risk management due to technological advances. The current trading systems provide live notifications, automated stop-loss orders, and portfolio tracking systems enabling investors to react promptly to shifts. These characteristics allow participants to use strategies accurately, restrict possible losses, and introduce suitable changes quickly, without constant monitoring. Advanced platforms also allow investors to backtest strategies using historical data, simulate different market conditions, and evaluate the effectiveness of various risk management techniques before applying them in live markets.
Education plays a significant role in strengthening the risk management practices. The participants are taught through courses, online tutorials, online webinars, and discussion forums about the analysis of trends, the creation of strategies grounded on scenarios, and hedging techniques. Exploitation of these assets assists the traders and investors to make better decisions and work towards having a disciplined attitude towards opportunities and risks. Learning from experts and more experienced traders gives participants insights into market behavior, common pitfalls, and proven strategies that reduce exposure and enhance returns.
Diversification has been a trendy risk mitigation measure. This may be carried out alongside forex trading, equities, commodities and bonds among other monetary tools, to spread out the risk in various asset classes. Diversification helps reduce the losses incurred in a specific region by gains in the other thus balancing the returns. By diversifying into a variety of assets, industries and regions, one will reduce the impact of shocks in the market and increase the chances of making steady profits.
There’s also a social network that enhances risk awareness. Members can learn more about risk management, disciplined trading, and different methods they can apply to their trading. Social trading platforms enable investors to communicate and share strategies, account performance, and example strategies of more experienced investors. This enables investors to gain insights, assess their own strategies and better understand market forces.
The compliance with regulations also plays a key role in providing a safe trading environment. The South Korean brokers include advice on account protection, ethical trading and disclosure. The participants will be in a position to focus on bringing the strategies to practice without any apprehension that operational risks are curbed by procedural safeguards and that the trading environment is equitable. Knowing the regulatory framework will allow investors to work on strategy implementation without having an anxiety of making a legal or procedural mistake.
Cloud and mobile solutions increase access to risk management tools. Investors can monitor positions, trade and amend them wherever they are. This helps them react to sudden market flows on time. This flexibility results in the fact that risk management is viable and continuous even to a manager who has to deal with portfolios among other professional and personal commitments. Mobile platforms and cloud-based analytics also allow investors to coordinate with financial advisors, access research materials, and review market data on the go, ensuring informed decisions at all times.
It demonstrates how Korean investors balance opportunity and prudence by integrating structured risk management practices. Market analysis and diversification, technology, education, social influence, and regulation, all help participants to navigate successfully through the market. The use of forex trading as part of these approaches offers further diversification opportunities to increase portfolio size and manage the impact of unexpected market events, leading to sound investment decisions. In these ways, investors are able to control risks and exploit good opportunities in both local and global markets.